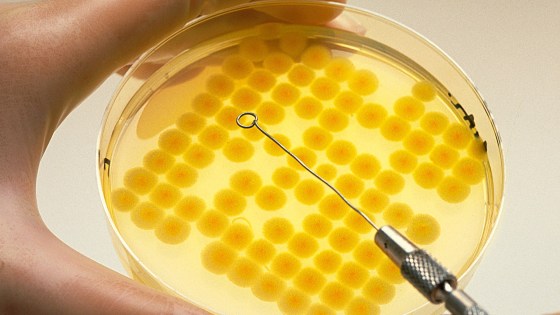

Historie BASF

1965 - 1989 Na cestě stát se nadnárodní společností
U stého výročí od svého založení v roce 1965 je společnost BASF již na cestě stát se nadnárodní společností: zprovozněním zahraničních výrobních závodů a dalšími investicemi ve Spojených státech společnost posiluje svou přítomnost ve vysoce industrializovaných zemích a trzích po celém světě.
Velké úsilí je věnováno výrobě zušlechtěných produktů. Ve výročním roce 1965 (100 let od založení společnosti) BASF získává výrobce Glasuritu a jednoho z největších evropských výrobců nátěrových hmot - firmu M. Winkelmann AG. Převzetí společnosti Dr. Beck & Co. AG v roce 1967 přispívá k rozšíření druhů produktů na bázi Glasuritu - tato společnost se zabývá výrobou izolačních nátěrů pro elektrotechnický průmysl. V roce 1968 BASF rozšiřuje své portfolio produktů o průmyslové a stavební nátěrové hmoty díky zakoupení většinového podílu ve společnosti Herbol-Werke Herbig Haarhaus AG. V 1970 posiluje BASF svou pozici na poli výroby pigmentů a tiskařských barev převzetím společnosti Siegle a Kast a firmy Ehinger. Toto rozrůstání společnosti položilo základy divize BASF Coatings, která je dnes jedním ze tří největších světových výrobců barev a laků pro automobilový průmysl.

V roce 1966 začíná s výrobou továrna BASF na magnetické pásky ve Willstättu v Německu. Vyrábí audio a videokazety, elektronická paměťová média a tiskové desky pro grafický průmysl. V Barceloně je založena společnost BASF Espaňola S.A. V roce 1969 začíná s výrobou Styroporu v Tarragoně. Dnes je Tarragona jedním z nejdůležitějších podniků BASF v Evropě. Vedle Styroporu dále vyrábí disperze, katalyzátory, zemědělské pesticidy a UP pryskyřice. V roce 2003 je v Tarragoně uveden do provozu jeden z největších závodů na dehydrogenaci propanu na světě.
V roce 1967 je novým spojitým procesem vyroben anhydrid kyseliny ftalové, důležitý prekurzor pro plastifikátory, a to na bázi o-xylenu namísto naftalenu jako suroviny.
Akvizicí společnosti Nordmark-Werke začíná působení společnosti BASF ve farmaceutickém průmyslu. V roce 1975 se společnost v této oblasti dále angažuje akvizicí Knoll AG.
Fúze se společností Wintershall AG, jednou z nejstarších německých společností v oblasti zpracování ropy a zemního plynu, v roce 1969 poskytuje společnosti BASF přístup k vlastním výchozím petrochemickým produktům. BASF získává společnost Wyandotte Chemicals Corporation z Wyandotte v Michiganu, která má hlavní závody ve Wyandotte a v Geismaru v Louisianě, a silně tak expanduje do Spojených států. V kombinaci s odbornými znalostmi ve společnosti BASF otevírá silná pozice této americké firmy v oblasti chemických surovin a polyuretanové chemie dveře k chemické rafinaci, která vede k výrobě lukrativních produktů, jako jsou zemědělské pesticidy a organické meziprodukty.

Současná akvizice skupiny Elastomer/Elastogran v Evropě (100% majetková účast byla získána v roce 1971) razí cestu pro vstup společnosti BASF do oblasti výroby polyuretanů – pěnových plastů, které mají široké uplatnění v automobilové výrobě i ve výrobě sportovních a volnočasových produktů. Dochází k rozšíření portfolia technických plastů: Ultraform GmbH, založená společně se společností Degussa v roce 1969, začíná v roce 1971 s výrobou acetalových kopolymerů. Ultraform je vhodný pro všechny aplikace, ve kterých hraje velkou roli tuhost, přesnost a velká míra tření a opotřebení. Od roku 1974 je součástí figurek Playmobil u intenzivně namáhaných dílů, jako jsou kyčelní klouby a ruce.


V Ludwigshafenu začíná s výrobou provoz na výrobu akrylové kyseliny jako derivátu polypropylenu. Nové zařízení nahrazuje předtím používanou metodu podle Reppeho chemie na bázi acetylenu a vede k průlomu v oblasti technologie zpracování. V roce 2014 má vedoucí postavení na trhu ve výrobě čisté kyseliny akrylové a akrylových esterů. Jsou to suroviny pro širokou řadu aplikací a koncových produktů počínaje nátěrovými hmotami přes lepidla, produkty na úpravu vody a plasty po saponáty a textilní vlákna. Kyselinu akrylovou lze najít ve formě polyakrylátu stejně jako v superabsorpčních plenkách.
V roce 1980 je v Ludwigshafenu uvedena do provozu jedna z největších jednotlivých investic společnosti BASF. Parní krakovací zařízení II. stojí 400 miliónů německých marek. Stejně jako parní krakovací zařízení I. dokončené v roce 1965 vyrábí krakovací zařízení II. klíčové produkty etylen a propylen z primárního benzínu (nafty). V Jižní Koreji zřizuje BASF společný podnik s firmou Hyosung. V roce 1982 začíná s výrobou Styroporu a v roce 1985 s výrobou Polystyrolu. V roce 1988 je založen druhý společný podnik na výrobu MDI, přípravného produktu pro polyuretan.
V roce 1982 je v Ludwigshafenu uveden do provozu vývoj v oblasti vůní: závody, které používají patentované procesy BASF na výrobu citronelalu, citronelolu a hydroxycitronelalu. Tyto látky se používají jako vonné složky mýdel a saponátů.
BASF je průkopníkem v biokatalytické výrobě vitaminu B2. V roce 1987 je dostupný postup, o tři roky později je chemická syntéza vitaminu B2 v provozu v Ludwigshafenu nahrazena fermentačním procesem. Jednou z výhod je, že využívá obnovitelné zdroje. Od roku 2003 BASF vyrábí tímto postupem vitamin B2 ve svém provozu v Gunsanu v Jižní Koreji. Jednou z hlavních možností využití je aditivum pro krmiva, Lutavit B2.

Velká investice do životního prostředí - po investici 200 milionů marek je spuštěno odsiřovací zařízení filtrující zplodiny ústřední uhelné elektrárny v Ludwigshafenu. Druhá část redukce exhalací je v provozu od roku 1990 - je to zařízení pohlcující oxidy dusíku. V roce 1989 začíná pracovat nové monitorovací středisko životního prostředí v Ludwigshafenu. Středisko sbírá data ze 43 monitorovacích stanic (dnes jich je 46). Stanice sledují přízemní znečištění vzduchu, sílu a směr větru a další meteorologické údaje v areálu a okolí. Měří se množství oxidů síry a dusíku, oxidu uhelnatého, ozonu a prachových částic nebo organických uhlíkatých látek. Sledována je i voda z chladících okruhů, stejně jako toximetry na přítoku do čističky.